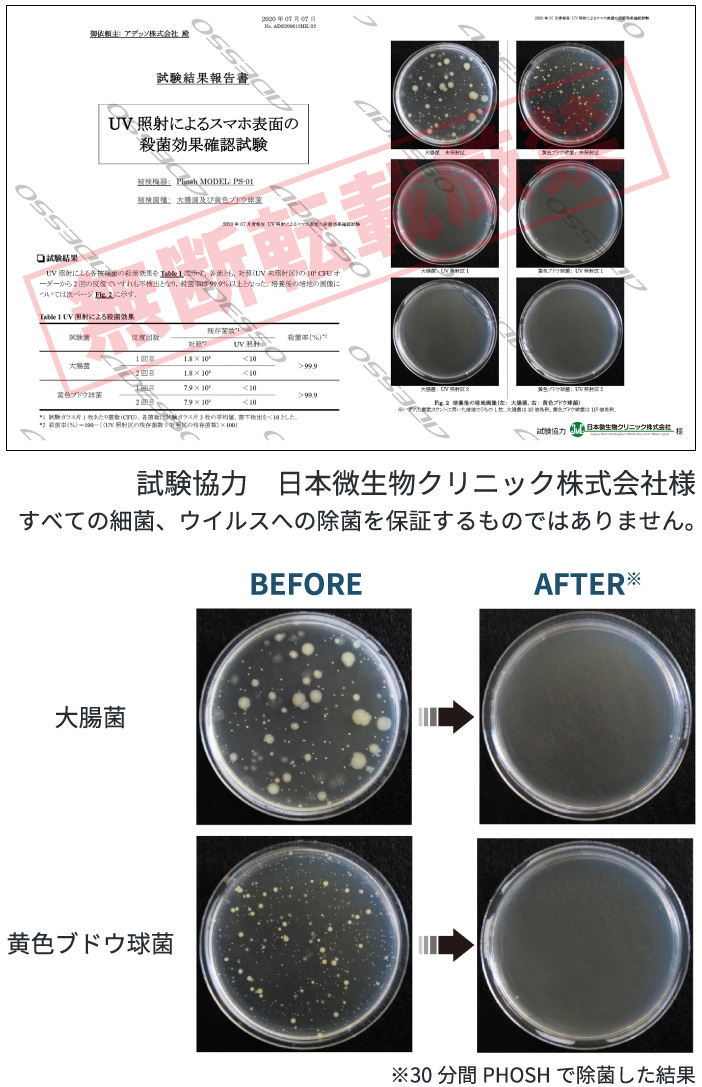
スマホを洗う？UVのチカラでスマホを除菌ADESSO

PHOSH スマホを洗う?UV (紫外線)のチカラでスマホを除菌! スマホを洗う?UVのチカラでスマホを除菌ADESSO
(4004件)
Pontaパス特典
サンキュー配送
7350円(税込)
74ポイント(1%)
Pontaパス会員ならさらに+1%ポイント還元!
送料
(
)
4006
配送情報
お届け予定日:2026.06.02 2:50までにお届け
※一部地域・離島につきましては、表示のお届け予定日期間内にお届けできない場合があります。
ロットナンバー
70151166721
お買い物の前にチェック!

Pontaパス会員なら
ポイント+1%
ポイント+1%
商品説明



















Phoshの特徴●視界から完全にスマホを隠す→集中力を向上させ、ストレス軽減●ワイヤレス充電機能(Qi対応)→スマホを収納するだけで充電可能●UV除菌機能→紫外線(UV)照射によりスマホ表面を手軽に除菌●ロックなしで安心→必要なときにすぐ取り出せる設計【仕様】機能クオーツ ワイヤレス充電(対応機種のみ)USB充電液晶明るさ切替(4段階)アラーム スヌーズ 日付表示12/24時間制表示 UV除菌除菌終了アラーム(ON/OFF切替可)除菌カウントダウン除菌自動終了(30分)スペックQi出力:5WUSB出力:5V/1A消費電力:最大15W入力:5V/3AUV波長:253.7nmUVバルブ数:3個UVバルブ寿命:13000時間商品サイズ/商品重量高:84mm✕幅:215mm✕奥行:133mm/614gUVボックス内サイズ高:1.6cm✕幅:16.7cm✕奥行:9.3cm化粧箱サイズ/化粧箱重量高:93mm✕幅:289mm✕奥行:148mm/826g材質ABS櫢脂電源ACアダプター(付)JAN4562102947356(16)名入場所/名入スペース天面(ロゴの上、または下) 35x150mm
| カテゴリー: | 生活家電・空調>>>生活家電>>>その他 |
|---|---|
| 商品の状態: | 新品、未使用","新品で購入し、一度も使用していない |
| 配送料の負担: | 送料込み(出品者負担) |
| 配送の方法: | 佐川急便/日本郵便 |
| 発送元の地域: | 愛知県 |
| 発送までの日数: | 1~2日で発送 |
レビュー
商品の評価:




 4.3点(4004件)
4.3点(4004件)
- RyutaJoy
- 注文して2日で届きました!早いっ! DC61につけるように買いました。最初の装着時、カチッとハマらない・・。ちゃんと合うのか何度もチェックしたので間違いは無いはず・・。 押し込んだらハマりました。少し硬いです。 使用感も問題なし。ありがとうございました!
- CB45
- 早速届きました。予備として使用しる予定で購入します。
- しおりん&M
- 逆止弁が壊れて困っていましたが、 このパーツが購入出来て良かったです。
- KOARA YU
- 互換性は全く問題ありませんでした。正規品に比べ、コスパが抜群だと思います。 注文番号335769-20210718-01357818
- RUMI0711
- サイクロンアタッチメント最高です。仕事がら粉塵を吸うのでフィルターのめずまりから解放されました。
- フェイくん
- まだ商品は到着していませんが、ランニングコストが抑えられるため購入しました。 期待しています! 注文番号 335769-20210705-01250805
- paruku
- 今回はロボット掃除機の回転ブラシを注文しました。小さなものでも、無いと気になるものだったので、ブラシ部分がちぎれてすぐに注文しました。とても素早い対応をしていただきとても感謝しています。
- ミィ友
- 掃除機も買ったは良いが、壁に穴を開けたくなくスタンドも購入しました。 簡単に組み立てられ余分にビスも着いていて助かります。
- ap2s2000
- 配送はとても早くてすぐ届きました。 部品の取外しと取付が大変だったらしく、旦那様がかなりイライラしながらやっていました(笑) ちゃんと取付られなかったらしいのですが、掃除機に戻したらちゃんとブラシが回転したので、一応成功です!!
すべて見る
お店の情報
7,367
連絡・応対
4.3
配送スピード
4.3
梱包
4.3